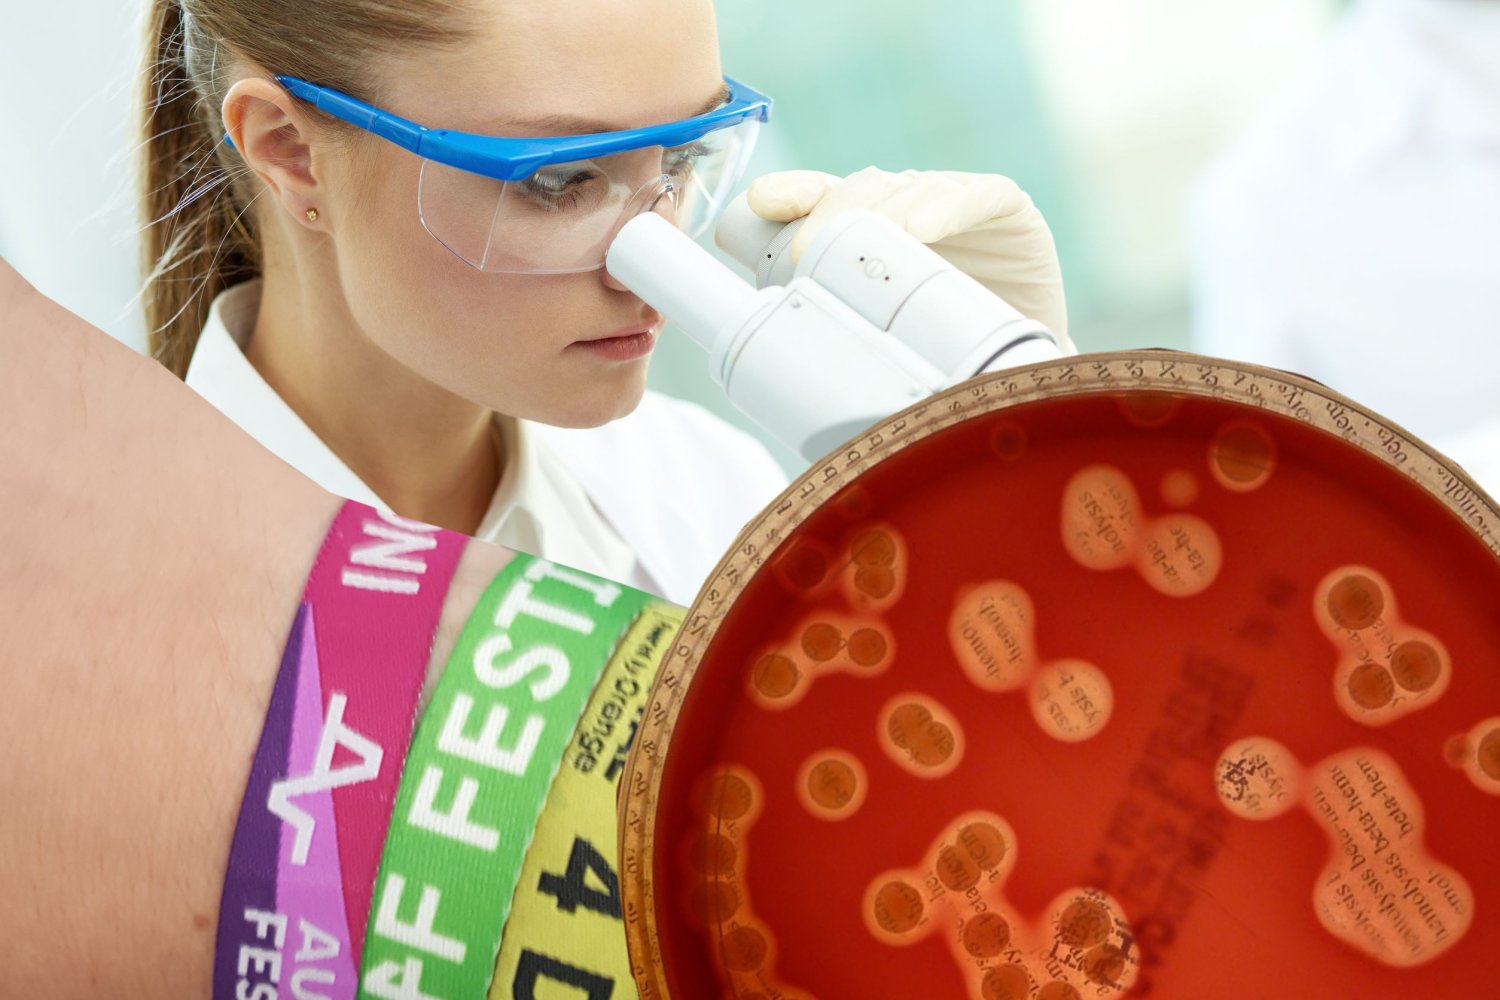

Barwny materiał festiwalowych opasek zamienił na zimną stal policyjnych kajdanek. Dziesięciotysięczną rodzinę drobnoustrojów z grupy gronkowców i ponad pięciotysięczne skupisko Gram-dodatnich paciorkowców ma na sumieniu 24-letni Marek M. z krakowskich Swoszowic – podała Wojewódzka Stacja Sanitarno - Epidemiologiczna w Małopolsce.
REKLAMA
Mężczyzna po powrocie z OFF Festivalu zakończył swój letni sezon i bez skrupułów rozciął wszystkie opaski z tegorocznych muzycznych imprez. W mieszkaniu 24-latka pracuje już policja i prokurator. Zabezpieczono nożyczki.
– Kolonie straciły dziś jedynego żywiciela – potwierdziła dr Marzena Karaś z małopolskiego sanepidu. – Na podstawie analizy hasztagów z jego Instagrama oraz historii podróży w PKP ustaliliśmy, że 24-latek od miesięcy krążył po Polsce i zapraszał na swoje nadgarstki niewinne i naiwne mikroorganizmy.
Lekkomyślnemu festiwalowiczowi grozi zarzut znęcania się nad podopiecznymi z całego kraju. Mroczne żniwo działalności mężczyzny jest naprawdę imponujące. Śledczy twierdzą, że jego nadgarstek był prawdziwą płytką Petriego.
– Wśród najciężej poszkodowanych są warszawskie ziarenkowce z Justice na Orange Warsaw Festivalu, grupa trójmiejskich przecinkowców z Foo Fighters na Open'erze, pasożyty z Białegostoku i Halfwaya, a także grupa odpornych na BPM wiślanych bakterii E.coli z Audiorivera w Płocku i Taurona w Katowicach – twierdzą mundurowi.
Wciąż nie wiadomo, dlaczego w chorej głowie festiwalowicza pojawił się zamiar skazania wyhodowanej mikroflory na pewną śmierć. Policjanci twierdzą, że sprawca był w szoku i podczas zatrzymania zapewniał, że było to dla niego decyzja trudniejsza i cięższa niż dla poszkodowanych drobnoustrojów.
– Mówił, że właśnie zginęła część jego wspomnień, muzycznych odkryć i festiwalowych przyjaźni, a także, że czuje się jakby zdradzał samego siebie, i że dla niego to już symboliczny koniec lata – zdradzają ASZdziennikowi śledczy.
– I bronił się tylko tym, że chciał jedynie zrobić miejsce na opaski z Kraków Live Festivalu, Soundrive'a, Unsounda i Ars Cameralis.
To jest ASZdziennik. Wszelkie cytaty i wydarzenia zostały zmyślone.
Autor: Łukasz Jadaś /@lukaszjadas
